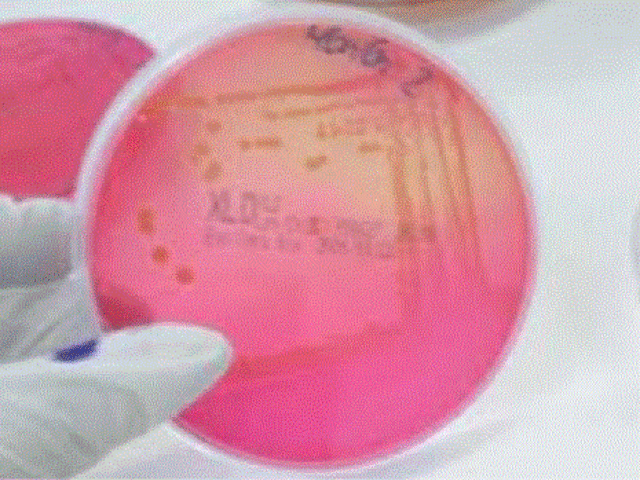
USO DE INDICADORES DE PH EN LOS MEDIOS DE CULTIVO

-
http://www.curtisbiologia.com/p1668
Para dilucidar si era cierta la noción de que los gusanos surgían por generación espontánea o si estos organismos tenían otro origen, Redi llevó a cabo un experimento en el que puso carne de serpiente recién muerta en un grupo de recipientes de boca ancha, algunos con tapas, algunos cubiertos con una tela delgada y otros abiertos, y observó que las larvas solamente aparecían en los frascos abiertos. -
http://datateca.unad.edu.co/contenidos/203015/moduloexe/leccin3.html
En 1675 descubrió que en una gota de agua de estanque pululaba una asombrosa variedad de pequeñas criaturas a las que denominó “animálculos”. En 1683 descubre las bacterias, por lo que se considera el “padre de la Microbiología” -
https://goo.gl/K8KAI8 (Pag. 1047)
Son los procariontes mas simples que se conocen con capacidad de autorreplicación. Cuando se les detecto como causantes de infecciones en el ganado (la pleuroneumonia, con altas tasas de mortalidad), se pensó que era un virus por tener la caracteristica de flitración.Este padecimiento se descubrió en el ganado, primero en Alemania en 1693 y posteriormente en Estados unidos, En 1843. -
http://goo.gl/KN02rD
Identifica por primera vez a un microorganismo (un hongo) como el agente etiologico de una enfermedad cutanea (pitiriasis versicolor).
La pitiriasis versicolor, o tinea versicolor, es una infección
fúngica superficial de la piel que se caracteriza por cursar
con cambios en la pigmentación cutánea, debidos a la colonizació del estrato córneo por hongos lipofílicos dimórficos pertenecientes al género Malassezia spp., que forman partede la flora normal de la piel. -
Hizo un gran descubrimiento en la bacteriología moderna. La primera prueba experimental de un agente biológico como causa de una enfermedad epidémica la proporcionó Agostino Bassi en 1835, que pudo demostrar que cierta enfermedad del gusano de seda, que había hecho su aparición en Lombardía, se debía al hongo Botrytis bassiana.
-
Descubre un hongo (Phytophthira infestans) que produce la podredumbre de la patata.
-
http://goo.gl/MZbqk4
http://goo.gl/oeYmT8
La muerte del profesor de medicina legal, herido por uno de sus discípulos durante una autopsia, con un cuadro septicémico similar a la infección puerperal, hizo pensar a Semmelweis que en los cadáveres había "materias pútridas" que los estudiantes portaban en sus manos desde la sala de disección a las parturientas, contaminándolas. Como consecuencia de ello, se les obligo a los estudiantes a lavarse las manos antes de tocar a las parturientas. -
http://www.losmicrobios.com.ar/microbios/?page_id=1158
Fueron varios los aportes de Lister, pero su trabajo más importante fue el triunfo sobre la infección de las heridas. Estaba convencido de que las heridas se podían liberar de las bacterias si se las protegían con la aplicación de una sustancia que matara a los microbios. Así sentó las bases de su método antiséptico. -
Propuso la clasificacion de las bacterias : Genero, Especie y variedades
-
http://sisbib.unmsm.edu.pe/bibvirtual/libros/medicina/ima_histo_med_per/cap_18.htm
Hansen realiza el descubrimiento del bacilo en 1873, observando en preparaciones frescas tomadas de lepromas y sin coloración previa, la presencia de bastoncitos rectilíneos resistentes a la acción de la potasa. La naturaleza microbiana de estos bastoncitos fue establecida en 1879 por Neisser quien pudo colorearlos adoptando la técnica de Ziehl-Neelsen. -
https://goo.gl/K8KAI8
El género Borrelia de la familia Spirochaetaceae, contiene 18 especies conocidas, de las cuales diez ifectan al hombre; nueve de ellas le producen fiebre recurrente endémica y una, Borrelia recurrentis, le produce fiebre recurrente epidémica.
Borrelia recurrentis fue descrita en la sangre de pacientes por primera vez en 1873, por Obermeier.Es una bacteria que midea de 8 a 16 micras de longitud, por 1 a 3 micras de espesor, sus extremos son afilados y es muy móvil. -
http://goo.gl/Q3Mc3b
A los 28 años Robert Kochr ecibió de su mujer el regalo de un microscopio e instaló un pequeño laboratorio en su casa. Allí hizo su primer y gran descubrimiento: el Bacillus anthracis, cuyo ciclo con esporas describió en detalle. Era la bacteria del carbunco y era la primera vez que se descubría la causa bacteriana de una enfermedad de los animales y del hombre. El trabajo, muy elogiado por eminentes colegas, apareció en 1876. -
http://diariojudio.com/opinion/neisser-descubridor-del-gonococo/1584/ En 1879 Neisser identificó la bacteria, a la que bautizó “gonococo”, obviamente relacionándolo al nombre de la enfermedad.una bacteria de forma redonda que vio en el pus de la gonorrea.
En su honor, el germen es hoy llamado Neisseria Gonorrhea. Tardarían otros 65 años para que la curación de la enfermedad fuera posible, gracias al descubrimiento de la penicilina. -
Encuentra al parasito de la malaria en los glóbulos rojos.
-
http://www.contactomagazine.com/finlay.htm
El médico cubano Carlos J. Finlay descubrió a finales del siglo XIX que el mosquito Aedes Aegyti era el trasmisor de la fiebre amarilla. Con este hallazgo, el Dr. Finlay ayudó a salvar millones de vidas en todo el mundo. -
http://www.britannica.com/biography/Robert-Koch#ref267351
Koch concentró sus esfuerzos en el estudio de la tuberculosis, con el objetivo de aislar a su causa. Aunque se sospechaba que la tuberculosis fue causada por un agente infeccioso, el organismo aún no había sido aislado e identificado.Al modificar el método de tinción, Koch descubrió el bacilo de la tuberculosis y estableció su presencia en los tejidos de animales y seres humanos que sufren de la enfermedad. -
http://goo.gl/Ze8gfo
Tinción de Gram es un método de diferenciar especies bacterianas en dos grandes grupos. El nombre proviene de su inventor, Hans Christian Gram.
Gram ideó su técnica no con el propósito de distinguir un tipo de bacteria de otro, pero para permitir que las bacterias se vean más fácilmente en las secciones teñidas de tejido pulmonar. Él publicó su método en 1884, e incluyó en su informe resumen de la observación de que el bacilo de la tifoidea no retuvo la mancha. -
http://goo.gl/MdUMR8
http://goo.gl/1n5YfE
Pasteur, descubre la vacuna de la rabia. Inocula saliva de un perro rabioso a un conejo, deseca la médula y la inocula la vacuna al joven José Meister, que había sido mordido 14 veces por un perro rabioso. Se conoce ya que la experiencia tuvo éxito. José Meister sobrevivió y se cuenta que años después era portero del Instituto Pasteur hasta bastante avanzado el siglo XX. -
http://blog.ciencias-medicas.com/archives/1373 Es una bacteria común que vive en los intestinos de animales y humanos.Fue descrita por primera vez en 1885 por Theodore von Escherich, bacteriólogo alemán, quien la denominó Bacterium coli. Posteriormente la taxonomía le adjudicó el nombre de Escherichia coli, en honor a su descubridor.
-
introduce el uso de las placas Petri en Microbiologia y en la bacteriologia
-
En 1890 Loeffler logra visualizar
flagelos bacterianos por medio de su técnica de impregnación argéntica -
Fue Würtz quien, en 1892, introdujo el uso de indicadores de pH Incorporados en los medios, lo cual permitía revelar la producción de acidificaciones por fermentación en ciertas bacteria.
-
http://www.nationalgeographic.es/ciencia/salud-y-cuerpo-humano/peste
La causa de la peste no se descubrió hasta la epidemia más reciente, que se inició en China en 1855 y que oficialmente no terminó hasta el año 1959. El primer descubrimiento tuvo lugar en Hong Kong en 1894 cuando los investigadores pudieron aislar el bacilo (con forma de vara), causante de la enfermedad, el Yersinia pestis. -
https://www.clinicalascondes.com/area_academica/Revista_Medica_Enero_2002/articulo_006.htm El nacimiento oficial y reconocido de la Penicilina se da en septiembre de 1928, por Alexander Fleming.
-
http://www.curtisbiologia.com/b1928
En 1928 se desarrolló un experimento que, en ese momento, pareció de poca importancia para el campo de la genética.
estaba estudiando la posibilidad de desarrollar vacunas contra Streptococcus pneumoniae, un tipo de bacteria que causa una forma de neumonía. En aquellos días, antes del desarrollo de los antibióticos, la neumonía bacteriana era una enfermedad grave. -
En 1938 se observaron por primera vez los virus gracias a la inveción del microscopio electronico
-
Albert Schatz aísla la estreptomicina de un cultivo de Streptomyces griseus. Su jefe, Selman Waksman, se apodera del descubrimiento y gana el premio Nobel de Medicina de 1952.
-
http://www.galileog.com/ciencia/biologia/adn/adn1.htm#descubrimiento
En 1952 Alfred Hershey y Martha Chase realizaron una serie de experimentos destinados a dilucidar si el ADN o las proteínas era el material hereditario. Marcando el ADN y las proteínas con isótopos radiactivos en un cultivo de un virus, se podía seguir el camino de las proteínas y del ADN en un experimento, demostrando cual de ellos entraba en la bacteria. -
La legionelosis es la enfermedad provocada por la bacteria. L. pneumophilia.
En el año 1965; 81 empleados del Hospital de Sta. Isabel en Washington padecen
neumonía, mueren 14 de ellos. La causa, entonces, no pudo detectarse. -
http://es.reuters.com/article/entertainmentNews/idESMAEA2O04W20140325
LONDRES (Reuters) - Peter Piot tenía 27 años, estaba recién titulado y trabajaba en un laboratorio de microbiología en Amberes cuando recibió un frasco de sangre con un misterioso patógeno que había estado matando a la gente en los bosques de Zaire.Esta historia tuvo lugar en Bélgica en 1976, cuando Piot y su equipo se convirtieron en los descubridores del Ébola. -
http://www.alpoma.net/tecob/?p=6672
El Variola virus, causante de la enfermedad, sólo encontraba acomodo en seres humanos y, al no existir ningún otro reservorio animal, las campañas de vacunación mundiales terminaron por acorralar y destruir al monstruo por completo.
El último caso de viruela se detectó en Somalia en 1977 y, desde entonces, la enfermedad que asoló al mundo desapareció por completo.Pero, he aquí que el caso de 1977 fue el último “natural”. -
Un gran avance en el estudio de las bacterias fue el descubrimiento realizado por Carl Woese en1977, de que las arqueas presentan una línea evolutiva diferente a la de las bacterias. Esta nuevataxonomía filogenética se basaba en la secuenciación del ARN ribosómico 16S y dividía a los procariotas en dos grupos evolutivos diferentes, en un sistema de tres dominios: Arquea, Bacteria y Eukarya.
-
http://todosobrediabetes.com/como-se-obtiene-la-insulin
Con la ingeniería genética se ha conseguido que la bacteria Escherichia Coli (E. Coli) pueda producir insulina. Esta insulina se le llama insulina con ADN recombinante.
n 1978 se consigue obtener la secuencia de insulina humana. Esta secuencia se introduce en el interior de la Escherichia Coli y se consigue que la bacteria produzca insulina. Es decir, con ingeniería genética se trasforma la E. Coli con una fábrica de producción de insulina. -
http://goo.gl/kcD36W
El síndrome de inmunodeficiencia adquirida, conocido por su acrónimo sida,1 es el conjunto de enfermedades de muy diverso tipo (generalmente, procesos infecciosos o tumorales) que resultan de la infección por el virus de la inmunodeficiencia humana (VIH).
Desde junio de 1981, cuando en Estados Unidos se registró el primer caso clínico de virus VIH, la epidemia de sida se extendió a todo el mundo y desde entonces han muerto al menos 22 millones de personas a causa del mal. -
Barry Marshall y Robin Warren demuestran el papel de Helicobacter pylori en la úlcera de estómago.
-
http://www.biocab.org/Vacas_Locas.html
Se descubrió que la transmisión de la enfermedad podía ocurrir de las ovejas al ganado vacuno y viceversa. Al indagar sobre esta forma de contagio, se “descubrió” el factor causal, el cual no era cualquier tipo de parásito conocido, sino fragmentos anormales de una proteína celular normal (PrPC), llamados priones (PrPSC).Los priones del tejido nervioso de un animal infectado se transmiten al animal sano a través del alimento. -
descubrieron Epulopiscium fishelsoni, la mayor célula procariota
-
Esta especie fue descubierta por Heide H. Schulz et al. en 1999, en la costa de Namibia. En 2005 se descubrió una especie muy cercana en el Golfo de México, planteándose así la posibilidad de que la Thiomargarita esté mucho más difundida de lo que se pensaba anteriormente. No hay otras especies en su género.
El récord anterior de tamaño lo ostentaba Epulopiscium fishelsoni, de 0,5 mm de longitud. -
http://www.who.int/mediacentre/f
El subtipo hiperpatógeno A(H5N1) infectó por vez primera al ser humano en 1997, durante un brote aviar registrado en la Región Administrativa Especial de Hong Kong (China). Desde su reaparición generalizada en 2003 y 2004, este virus aviar se ha propagado de Asia a Europa y África, y se ha arraigado en las aves de corral de algunos países, produciendo millones de casos de infección en estos animales, varios cientos de casos humanos y la muerte de muchas personas. -
https://www.nlm.nih.gov/medlineplus/spanish/ency/article/007192.htm
El síndrome respiratorio agudo y grave (SARS, por sus siglas en inglés) es una forma seria de neumonía. Es causada por un virus que se identificó por primera vez en el año 2003. La infección con el virus del SARS provoca una molestia respiratoria aguda (dificultad respiratoria intensa) y, algunas veces, la muerte. -
Según el epidemiólogo Luis Antonio Suárez, la pandemia de la influenza AH1N1, que empezó a circular en el 2009, afectó a casi el 40% de nuestra población, sin embargo en la actualidad este grupo de personas ya cuenta con anticuerpos protectores naturales, están en la capacidad de hacer frente al virus.